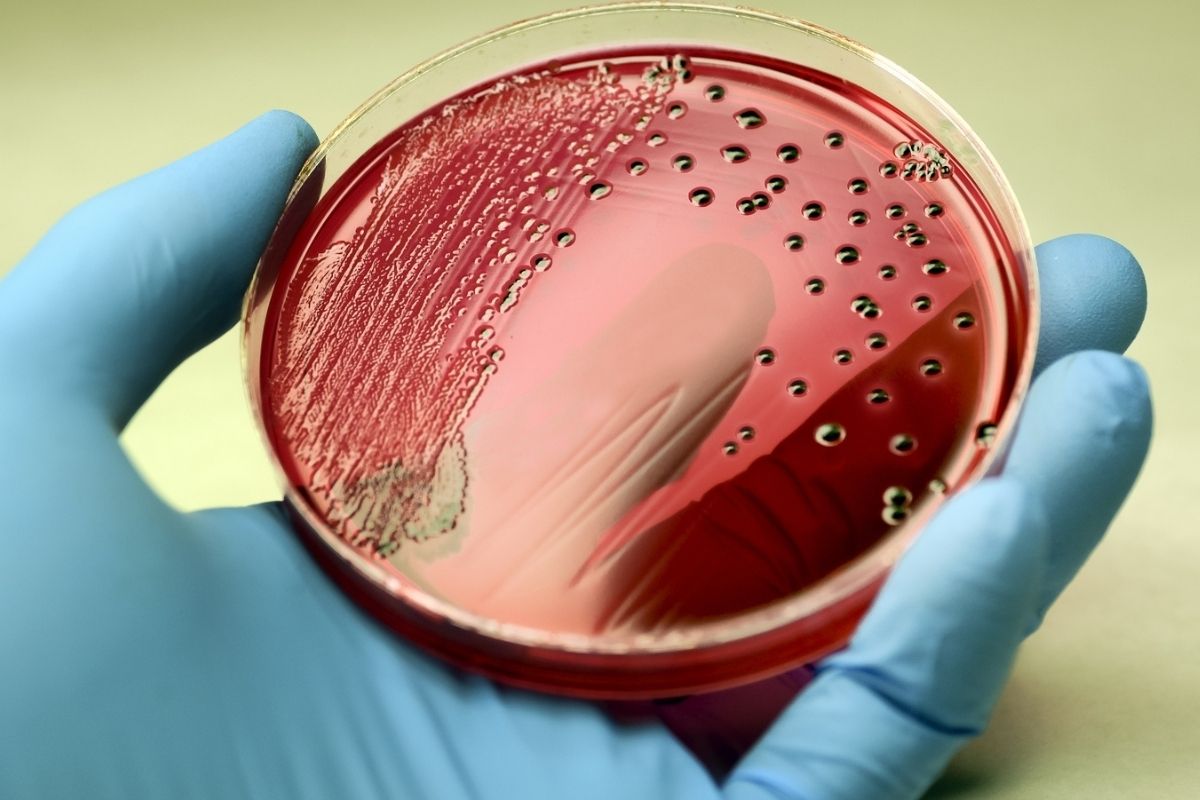

Inexpensive fruits and vegetables that are natural blood purifiers
आपको जानकर आश्चर्य होगा कि रोज खाई जाने वाली कई ऐसी चीजें है जो खून में गंदगी समाहित करती है। ये गंदगी वसा से लेकर हानिकारक पदार्थ तक हो सकते हैं। खराब खानपान और सुस्त जीवनशैली ही नहीं, कई बार खानपान के कारण ही कोलेस्ट्रॉल, हाई ब्लड प्रेशर, ब्लड सर्कुलेशन कम होने या ब्लड क्लॉट जैसी समस्याएं होती हैं। तो चलिए जानें किन चीजों से खून जहरीना बनता है।
अत्यधिक मीठी चीजें
मीठा चीजे खानें के शौकीन हैं तो आप खुद खून में जहर घोलने के जिम्मेदार हैं। मीठी चीजें न केवल डायबिटीज और मोटापे के कारण बनती हैं, बल्कि ये आपके खून को भी खराब करती हैं। आपको जानकर आश्चर्य होगा कि मीठी चीजें नमकीन चीजों के मुकाबले अधिक ब्लड प्रेशर बढ़ाती हैं।
नमकीन चीजें
नमकीन चीजों में सोडियम अधिक होता है इससे बीपी तो बढ़ता ही है कोलेस्ट्रॉल बढ़ने की संभावना भी अधिक होती है। प्रोसेस्ड और फास्ट फूड में आमतौर पर अत्यधिक मात्रा में सोडियम होता है। आपको खून को साफ रखने के लिए तुरंत पिज्जा-बर्गर जैसी चीजों का सेवन बंद कर देना चाहिए।
रेड मीट का सेवन
रेड मीट हाई कोलेस्ट्रॉल और हाई बीपी की वजह के साथ ही मेटाबॉलिक डिसॉडर का भी कारण होता है। शरीर में रेड मीट के चयापचय की प्रक्रिया से ऐसे यौगिक भी निकलते हैं जो रक्तचाप को और भी अधिक बढ़ाते हैं। जान लें कि मीट का रंग जितना लाल होगा उससे ब्लड प्रेशर बढ़ने की संभावना उतनी ही अधिक होगी।
प्रोसेस्ड और पैकेज फूड
पैकेज फूड हाई सोडियम से भरे होते हैं और ये किडनी के लिए हानिकारक है। खून में सोडियम जब अधिक होता है किडनी का फिल्टरेनशन पावर गड़बड़ होने लगता है। साथ ही ब्लड प्रेशर भी बढ़ता है।
शुगरी ड्रिंक्स और सोडा
कभी-कभार मीठा पेय पीना ठीक हो सकता है लेकिन हमेशा चीनी से भरपूर ड्रिंक्स पीने से ब्लड प्रेशर बढ़ सकता है। यह चीजें सीधे रूप से खून पर असर डालती हैं। इसके अलावा कई ड्रिंक्स में कैफीन भी होता है, जो ब्लड प्रेशर को बढ़ा सकता है।
इन चीजों से भी बना लें दूरी
ऊपर बताई गई चीजों के अलावा कई खाद्य पदार्थ और हैं, जो खून के स्वास्थ्य पर असर डालते हैं। अगर आप खून से जुड़े विकारों से बचना चाहते हैं, तो आपको शराब, सैचुरेटेड फैट, कैफीन वाली चीजें, सोडियम से भरपूर मसाले जैसे सोया सॉस, कैच-अप आदि से सेवन से परहेज करना चाहिए।
Published on:
01 Jun 2022 12:28 pm
बड़ी खबरें
View Allरोग और उपचार
स्वास्थ्य
ट्रेंडिंग
लाइफस्टाइल
